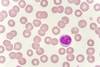
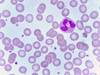
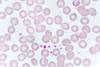
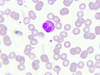
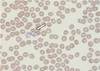
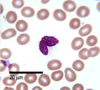
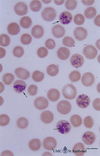
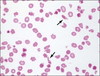
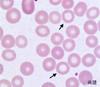
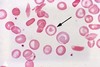
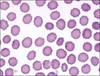
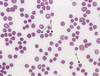
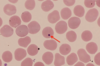

Microscope: blood sample Flashcards
(28 cards)

Red blood cells
Ca. 7 µm in diameter. Most numerous type of cell in blood. One microlitre of blood contains ca. 5 million cells. Essential for transport of CO2 and O2 around the body.
‘Born’ and mature in BM. When they mature, they make Hg. Eventually around 90% of the dry weight of the cell is made up of this protein. The nucleus is lost from the cell, phagocytosed by macrophages, and the DNA broken down. They can then enter the circulation.
Live for about 120 days. However, the iron in Hg is extracted from the erythrocytes by the liver and spleen, and the remaining heme is excreted by the liver as bile pigments.
Around 3 million RBCs die and are scavenged by the liver each second.
Lymphocyte
Most are small; a bit bigger than RBCs, about 6-9µm in diameter. The rest (around 10%) are larger, about 10-14µm in diameter. These larger cells have more cytoplasm, more free ribosomes and mitochondria.
Lymphocytes can look like monocytes, except that lymphocytes do not have a kidney-bean shaped shaped nucleus, and are usually smaller. Larger lymphocytes are commonly activated lymphocytes.
They have a small spherical nucleus and has abundant dark staining condensed chromatin. Not much cytoplasm can be seen, and it is basophilic (pale blue/purple staining).
These are the second most common WBC (20-50%), and are easy to find in blood smears.
Although the cells look similar there are two main types, B-cells and T-cells.
B-cells develop in the bone marrow. T cells are born in the bone marrow, but are matured in the Thymus.
Function:
The B-cells develop into plasma cells which make antibodies, The T-cells attack viruses, cancer cells, and transplants.
Neutrophil
12-14 µm diameter, and so look bigger than surrounding RBCs.
Single multilobed nucleus, can have between 2 and 5 lobes.
Commonest type of WBC found in a blood smear. Make up 60-70% of WBCs.
Neutrophils have 3 types of granules:
azure granules (lysosomes),
secretory granules in salmon pink cytoplasm, anti-microbial enzymes.
glycoproteins and gelatinase.
Function:
Born in BM. Circulate in blood for 6-10 hours, and then enter tissues. Motile, and phagocytic and will destroy damaged tissue and bacteria. They self destruct after one burst of activity.
Important in inflammatory reactions.

Monocyte
The largest type of white blood cells, can be up to 20µm in diameter.
Have a large eccentrically placed nucleus, which is kidney bean shaped.
Have abundant cytoplasm, and some fine pink/purple granules in cytoplasm.
Third most common type of WBCl; about 2-10% of leucocytes are monocytes.
Function:
In the circulation: precursors of tissue macrophages that are actively phagocytic. Circulate in the blood for 1-3 days, and then migrate into body tissues, where they transform into macrophages. They will phagocytose dead cells and bacteria. Some monocytes can also transform into osteoclasts.
Important in the inflammatory response.
RBCs and platelets

Basophil
14-16 µm in diameter, contain lots of deep blue staining granules (basic) and a bilobed nucleus. The granules contain heparin, histamine and serotonin. prostaglandins and leukotrienes.
Basophils are the rarest type of WBCs, making up only 1% of the WBCs found in a blood smear.
Function:
Involved in immune responses to parasites. Have IgE receptors and the granules are released when the cells bind IgE. These cells also accumulate at sites of infection, and the release of prostaglandins, serotonin and histamine help to increase blood flow to the area of damage, as part of the inflammatory response. The degranulation - release of histamine also plays a role in allergic reactions such as hay fever.
Eosinophil
12 - 17 µm in diameter - larger than neutrophils, and about 3 times the size of a RBC. Two lobes to their nucleus.
Have large acidophilic specific granules - stain bright red, or reddish-purple. These granules contain proteins that are ‘destructive’ and toxic.
Eosinophils are fairly rarely found in blood smears - making up 1-6% of the WBCs
Function :
Born in BM, migrate from peripheral blood system after a few hours, into loose CT in RT and GIT. Phagocytose antigen-antibody complexes. Produce histaminase, and aryl suphatase B, two enzymes that inactivate two inflammatory agents released by mast cells. A high eosinophil blood count may indicate an allergic reaction.
Also important in killing parasitic worms.

Macrophage
Platelet aggregation

Acanthocytes
Abnormal RBCs

Giant multinucleated cell

Bilirubin

Bile crystals in liver

Granulation tissue, poorly formed granuloma and giant Langerhans type cells
Monocyte

Basophil
Reticulocytes
Reticulocytes are newly produced, relatively immature RBC´s.
Abnormal appearance: increased production (regenerative anaemia) - chronic Fe deficicency anaemia, haemolysis, acute blood loss, chronic blood loss

Spherocytes
RBCs that are sphere-shaped rather than bi-concave disk shaped as normal.
Abnormal appearance: sensitive RBC membrane, IM hemolysis

Stomatocytes
RBC in which the central biconcave area appears slitlike/mouth-shaped.
Appearance: increased RBC production (regenerative anaemia)
Schistocyte
RBC fragment; irregular shaped, jagged and with two pointy ends
Appearance: traumatic or toxic damage (uremia, blood parasites, long term severe physical activity, DIC)
Anulocytes
0-shaped RBC / “punched out cell”
Appearance: iron deficiency anaemia
Codocyte
Also called Target cell - RBC that looks like a target.
Appearance: regenerative process
Echinocytes
“Burr cell” / “crenation” - RBC with many small spikes
(from Greek “Echinos” meaning “hedgehog” or “sea urchin”)
Appearance: laboratory error (too quick drying of blood film, uremia, DIC)

Sickle cells
Results in an abnormality in the haemoglobin found in RBCs. This leads to a rigid, sickle-like shape under certain circumstances. Also called “Drepanocyte”
Appearance: RBC damage, Hb globin chain malformation in humans, Sickle cell anaemia